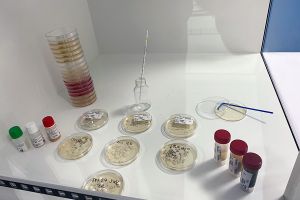
Des ferments d’affinage uniques et spécifiques

Qui sommes-nous?

LIP est l’unique structure interprofessionnelle franco-française du domaine.
Située à Aurillac, au cœur d’une zone de production de fromages AOP et de Terroirs, nous cultivons une grande diversité de micro-organismes pour répondre à toute la filière.
Nous commercialisons une gamme diversifiée de ferments composés de Levures, Moisissures et Bactéries qui sont destinés aux fabricants de fromages, charcuteries et alternatives végétales...
Nos atouts :
Des ferments d’affinage uniques et spécifiques

40 ans d’expériences dans la production de ferments d’affinage

Un savoir faire unique au sein d’un outil moderne de production

Un investissement de plus de 8 millions d’euros

Un engagement rse fort

Une équipe impliquée proche de ses clients

Un service R&D a votre écoute
Nous réalisons, également sur demande, et sous réserve de volume :
-
La multiplication de souche de votre propriété sous contrat d'exclusivité.
-
L'élaboration de références spécifiques à vos besoins.